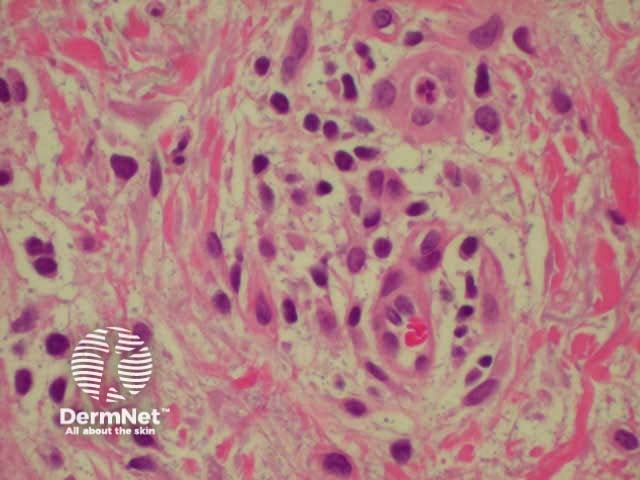
Dermal inflammatory infiltrate

Main menu
Common skin conditions
NEWS
Join DermNet PRO
Read more
Quick links
Created 2008.
Dermatitis and eczema are words that are often used interchangeably to describe a variety of distinct skin conditions in which there is epidermal and dermal inflammation and nearly always intense itching.
It is useful to distinguish ‘acute’, ‘subacute’ and ‘chronic’ forms of eczema.
Acute dermatitis is characterised by erythema, vesiculation and oozing, often with oedema.

Acute dermatitis

Acute dermatitis

Acute dermatitis
Subacute dermatitis is similar to acute dermatitis, but with scaling and crusting.

Subacute dermatitis

Subacute dermatitis

Subacute dermatitis
Chronic dermatitis is characterised by thickened dry patches, often lichenified from chronic rubbing (increased skin markings). Lichenification is often predominantly follicular in pigmented skin.

Chronic dermatitis

Chronic dermatitis

Chronic dermatitis
Lichen simplex chronicus describes localised patches of lichenification because of rubbing and scratching; the patches become increasingly itchy so it is difficult to stop scratching. It may be a complication of atopic dermatitis. Well-defined papules and bumpy thickened plaques are found most often in adults on the nape of the neck, occipital scalp, lower legs, forearms, vulva or scrotum. Widespread lichen simplex is often called neurodermatitis.

Upper back

Scrotum

Leg
Prurigo refers to skin lesions (papules or nodules) that itch intensely. It includes:

Prurigo due to insect bites

Widespread nodular prurigo

Close-up of excoriated nodular prurigo
Autosensitisation dermatitis is the rash that appears on the trunk and limbs due to generalisation of a previously localised condition such as asteatotic or venous eczema. It may appear similar to nummular dermatitis and can be intensely pruritic, requiring systemic steroids for control. An id reaction is autosensitisation dermatitis arising in response to a fungal infection.

Autosensitisation dermatitis

Autosensitisation dermatitis

Autosensitisation dermatitis
Histologically, dermatitis is characterised by inflammation of the epidermis and epidermis i.e perivascular lymphohistocytic infiltrate. The hallmark of acute dermatitis is spongiosis (intraepidermal vesicles). As eczema becomes more chronic, there is tendency for it to become more acanthotic (thickened epidermis) and less spongiotic.

Low-power view

Spongiosis
Dermal inflammatory infiltrate
Management of dermatitis involves:
When is scratching just a bad habit, and can it be avoided?
Information for patients
See the DermNet bookstore